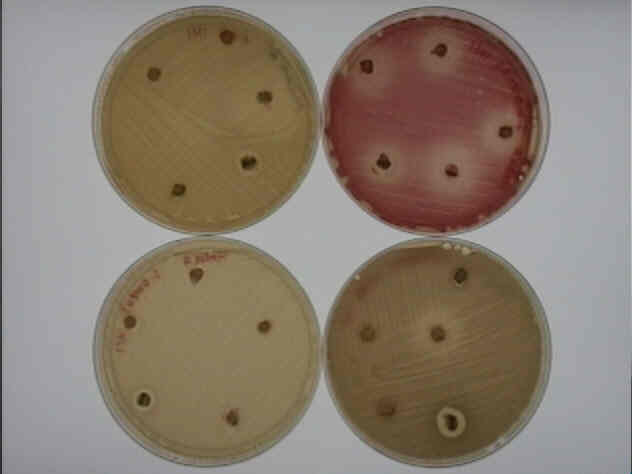
larger picture

Alsace Gallop and Allyson Morman
BSCI223H Fall
2000 Sect. 0101
Dr. Ann Smith
Abstract
* Introduction
* Media
* Procedure
* Results
* Discussion
Our
Theoretical Protocol * References
and Links

Alsace Gallop and Allyson Morman
BSCI223H Fall
2000 Sect. 0101
Dr. Ann Smith
Abstract
* Introduction
* Media
* Procedure
* Results
* Discussion
Our
Theoretical Protocol * References
and Links